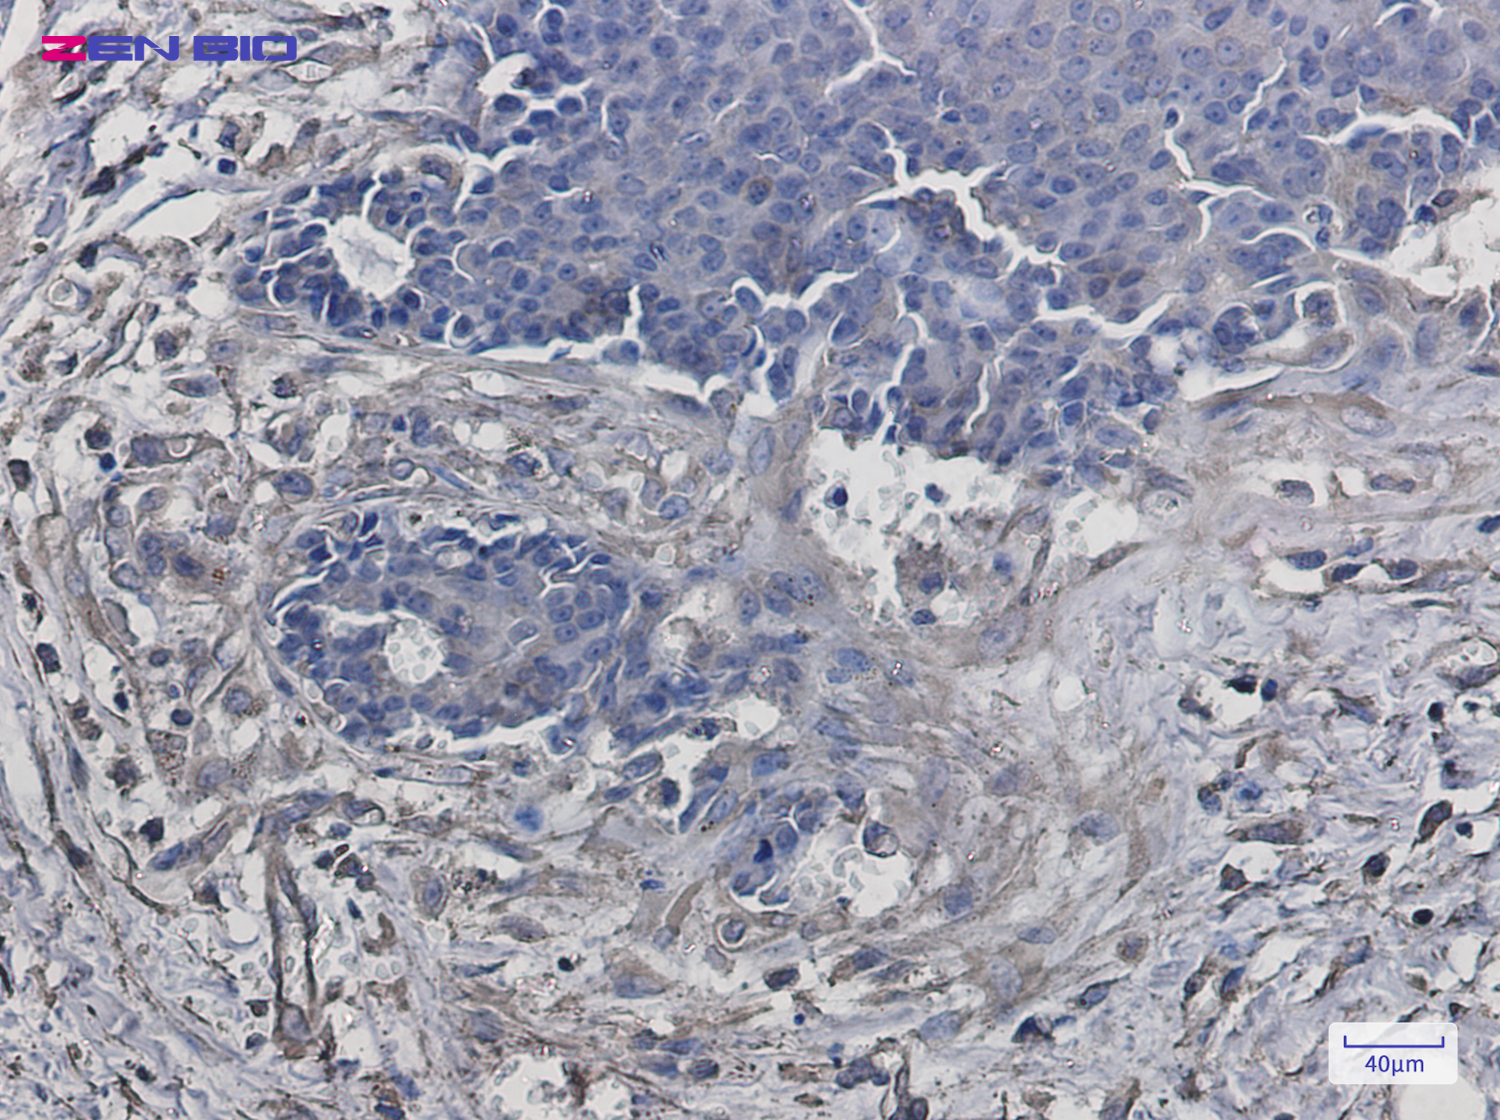

-
Product Name
Anti-VPS4a Rabbit antibody
- Documents
-
Description
VPS4a Rabbit polyclonal antibody
-
Tested applications
WB, IHC-P, ICC/IF, FC
-
Species reactivity
Human, Mouse, Rat
-
Alternative names
VPS4A antibody
-
Isotype
Rabbit IgG
-
Preparation
Antigen: A synthetic peptide of human VPS4a
-
Clonality
Polyclonal
-
Formulation
Supplied in 50nM Tris-Glycine(pH 7.4), 0.15M Nacl, 40%Glycerol, 0.01% sodium azide and 0.05% BSA.
-
Storage instructions
Store at -20°C. Stable for 12 months from date of receipt.
-
Applications
WB: 1/2000-1/10000
IHC: 1/500
ICC/IF: 1/100
FC: 1/20
-
Validations

Western blot detection of VPS4a in K562,Rat Brain,C6,3T3 cell lysates using VPS4a Rabbit pAb(1:1000 diluted).Predicted band size:49kDa.Observed band size:49kDa.
Immunohistochemistry of VPS4a in paraffin-embedded Human breast cancer tissue using VPS4a Rabbit pAb at dilution 1/50

Immunocytochemistry of VPS4a(green) in Hela cells using VPS4a Rabbit pAb at dilution 1/50, and DAPI(blue)
-
Background
Swiss-Prot Acc.Q9UN37.Involved in late steps of the endosomal multivesicular bodies (MVB) pathway. Recognizes membrane-associated ESCRT-III assemblies and catalyzes their disassembly, possibly in combination with membrane fission. Redistributes the ESCRT-III components to the cytoplasm for further rounds of MVB sorting. MVBs contain intraluminal vesicles (ILVs) that are generated by invagination and scission from the limiting membrane of the endosome and mostly are delivered to lysosomes enabling degradation of membrane proteins, such as stimulated growth factor receptors, lysosomal enzymes and lipids. In conjunction with the ESCRT machinery also appears to function in topologically equivalent membrane fission events, such as the terminal stages of cytokinesis and enveloped virus budding (HIV-1 and other lentiviruses). Involved in cytokinesis: retained at the midbody by ZFYVE19/ANCHR and CHMP4C until abscission checkpoint signaling is terminated at late cytokinesis. It is then released following dephosphorylation of CHMP4C, leading to abscission (PubMed:24814515). VPS4A/B are required for the exosomal release of SDCBP, CD63 and syndecan (PubMed:22660413).
Related Products / Services
Please note: All products are "FOR RESEARCH USE ONLY AND ARE NOT INTENDED FOR DIAGNOSTIC OR THERAPEUTIC USE"
